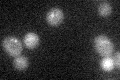
YBR097W
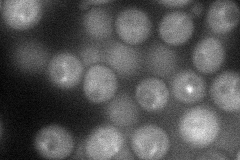
YBR097W
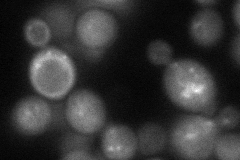
YBR097W
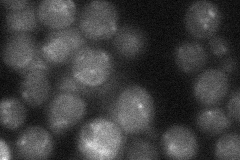
YBR097W

View description
Myristoylated serine/threonine protein kinase involved in vacuolar protein sorting; functions as a membrane-associated complex with Vps34p; active form recruits Vps34p to the Golgi membrane; interacts with the GDP-bound form of Gpa1p
Localization:
Intensity:
Fold change:
Significance:
-
C’ GFP library in SD
punctate18.26 -
N' NOP1pr-GFP in SD
punctate,vacuole membrane40.0635 -
N' TEF2pr-mCherry in SD
punctate,vacuole membrane47.8911 -
N' NATIVEpr-GFP in SD
punctate24.3795 -
N' TEF2pr-VC and Cyto-VN in SD

below threshold26.6035 -
C’ GFP library in SD+DTT

punctate20.951.14No -
C’ GFP library in SD+H2O2

punctate18.971.03No -
C’ GFP library in Starvation Media

punctate23.261.27No -
C’ GFP library on the background of Pup2-DaMP

punctate -
C’ GFP library on the background of CCT mutant

punctate16.850.922467No
